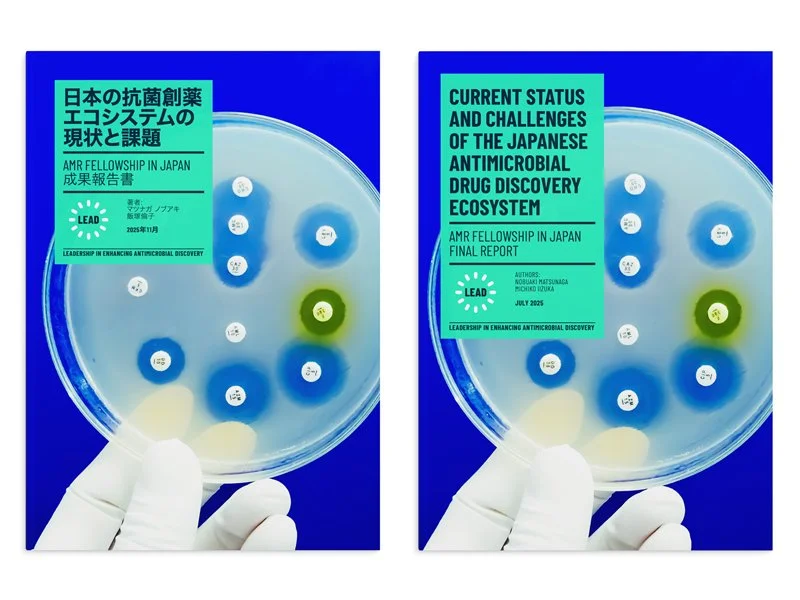
Magazine-0447-9B.jpg

The Alpine Room is a creative studio with roots in Frankfurt, Germany, and Brighton, UK. Here beautiful work is created, always for you, the client. We believe in the power of great ideas and the difference that good design can make. Please contact us if you would like to know more.
The view from The Alpine Room.
I was commissioned to design a new visual identity for LEAD: Leadership in Enhancing Antimicrobial Discovery, a global coalition tackling the urgent threat of antimicrobial resistance (AMR). As antibiotics lose effectiveness, new drug development is vital—but challenged by high costs and limited returns. LEAD brings together experts from science, policy, industry, and advocacy to strengthen global collaboration in antimicrobial discovery. The identity needed to express LEAD’s mission and values clearly, and work flexibly across international platforms ahead of its autumn 2025 launch.
I developed a new visual identity for the Respect Project at the Institute of Development Studies (IDS), a long-term effort to build a more inclusive and respectful workplace. The project was created in response to an Equity and Inclusion Review that raised concerns among younger, junior, and racially minoritised staff. With major components launching in 2025—including a Respect policy, external reporting platform, updated resolution processes, and a learning programme—the project needed a clear visual identity that fits the IDS brand while reflecting respect, culture change, speaking up, unity, and forward thinking. The identity is used across digital and print materials to support engagement and communication.
Brand refresh: Book Aid International
Brand identity for the Centre for Disaster Protection
Client: GOV.UK Department for International Development
Brand identity
Client: WE ARE FEMINIST LEADERS
Rebrand and Impact Report
Client: Lilongwe Wildlife Trust
Brand development, launch booklet & pop up banners.
Client: International Science Council
Toddler Lab hoardings, part of the Pentagram brand refresh.
Client: Birkbeck University of London
Supporter mailing
Client: National Trust
Registered in Germany 01482538767 © The Alpine Room 2026
Privacy Statement